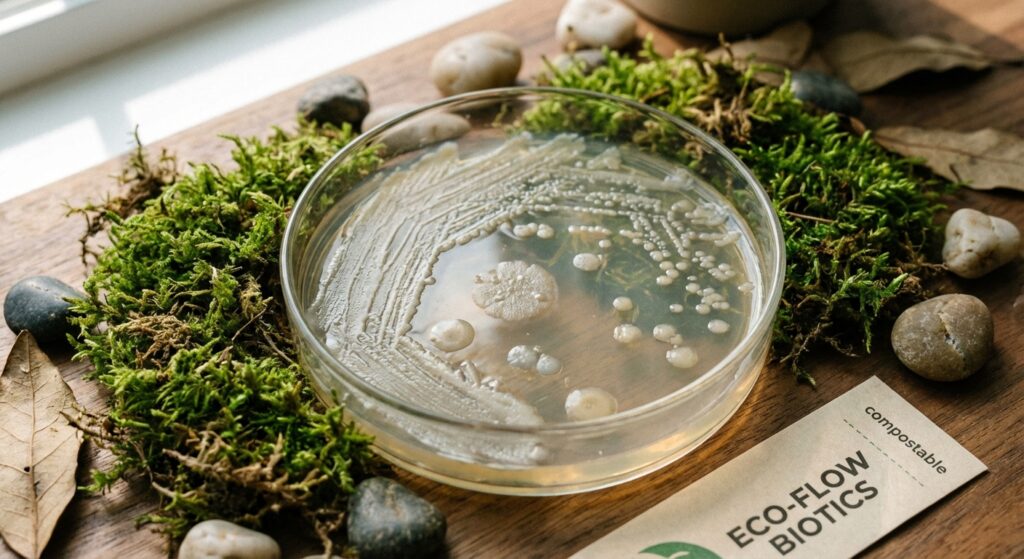
Biologinės bakterijos septikams, ekologiškas požiūris į nuotekų valymą

Biologinės bakterijos septikams ir jų esminiai skirtumai nuo cheminių priemonių
Biologinės bakterijos septikams yra natūralus ir efektyvus sprendimas, skirtas gerinti nuotekų valymo kokybę, išsaugant aplinką ir pačią sistemą. Šiame straipsnyje aptarsime, kuo biologinės bakterijos skiriasi nuo įprastų cheminių priemonių ir kodėl jos tampa vis populiaresniu pasirinkimu.
Biologinės priemonės veikia remdamosi mikroorganizmų aktivavimu, kurie skaidydami atliekas, padeda palaikyti septiko natūralią ekosistemą. Tai svarbi sąlyga efektyviam ir tvariam nuotekų valymui.
Tuo tarpu cheminės priemonės dažnai pasižymi agresyviu poveikiu, kuris gali trumpalaikiai pagerinti situaciją, bet ilgainiui pakenkti septiko mechanizmui ir aplinkai. Sužinokime daugiau apie šių priemonių skirtumus ir privalumus.
Kas yra biologinės bakterijos ir kaip jos veikia septike?
Biologinės bakterijos yra natūralūs mikroorganizmai, kurie aktyviai skaidina organines atliekas septiko talpyklose, palaikydami nuotekų valymo procesų pusiausvyrą ir efektyvumą.
- Mikroorganizmų vaidmuo skaidant organines atliekas: Mikroorganizmai skaidė atliekas, paverčia jas paprastesnėmis, mažiau kietomis medžiagomis, leidžiančiomis septikui funkcionuoti efektyviau.
- Pagrindinės bakterijų rūšys naudojamos septikuose: Dažniausiai naudojamos anaerobinės ir aerobinės bakterijos, kurios kartu užtikrina kompleksinį atliekų perdirbimą.
- Natūralūs procesai nuotekų valymo sistemoje: Biologinės bakterijos imituoja gamtos procesus, palaiko organinių medžiagų skilimą ir padeda išvengti nuosėdų kaupimosi.
Tradicinės cheminės priemonės septikams ir jų poveikis
Cheminės priemonės septikams dažnai remiasi sintetinių medžiagų sudėtimi, kurios greitai naikina bakterijas ir skaidomas atliekas, tačiau jos gali būti žalingos septiko ekosistemai ir aplinkai.
- Agresyvių cheminių medžiagų sudėtis: Dažniausiai jose yra chloro, formaldehidų ir kitų stiprių dezinfekantų, kurie naikina ne tik kenksmingus patogenus, bet ir naudingus mikroorganizmus.
- Trumpalaikis poveikis ir ilgalaikė žala sistemai: Nors cheminės priemonės gali greitai išspręsti problemą, jos naikina biologinę pusiausvyrą septike, ilguoju laikotarpiu blogindamos sistemos veikimą.
- Neigiamas poveikis aplinkai ir gruntiniams vandenims: Cheminės medžiagos gali patekti į gruntinius vandenis ir teršti aplinką, sukeldamos ekologinius sutrikimus.
Pagrindiniai skirtumai tarp biologinių ir cheminių valymo priemonių
Suprasti pagrindinius veikimo principus, saugumą ir poveikį septiko sistemai yra svarbu renkantis tinkamą priemonę.
- Veikimo principas ir greitis: Biologinės bakterijos veikia natūraliai ir pamažu didina efektyvumą, o cheminės priemonės veikia greitai, bet trumpalaikiai.
- Saugumas sistemos komponentams: Biologinės priemonės nekenkia septiko siurbliais, vamzdžiams ar filtrams, o cheminės gali sukelti koroziją ir mechaninę žalą.
- Poveikis biologinei pusiausvyrai: Biologinės bakterijos palaiko natūralią mikroorganizmų balansą, tuo tarpu cheminės priemonės šią pusiausvyrą griovina.
Kodėl biologinės bakterijos yra pranašesnis pasirinkimas?
Biologinės bakterijos siūlo efektyvią, saugią ir ekologišką alternatyvą cheminėms priemonėms, kuri padeda išlaikyti septiko veikimą ir aplinkos švarą.
- Efektyvi kamščių ir nuosėdų prevencija: Reguliariai naudojamos bakterijos neleidžia kauptis fekalinėms nuosėdoms ir riebalams.
- Nemalonių kvapų šaltinio naikinimas: Natūralus organinių medžiagų skilimo procesas mažina blogus kvapus.
- Ilgalaikis ir tvarus sistemos veikimas: Prisideda prie nuolatinės septiko talpos darbo kokybės be papildomos mechaninės intervencijos.
- Ekologiškumas ir saugumas gamtai: Bakterijos nesukelia taršos ir neužteršia gruntinių vandenų.
Kaip teisingai naudoti ir dozuoti biologines priemones?
Teisingas biologinių bakterijų naudojimas yra būtinas norint pasiekti maksimalią efektyvumą. Rekomenduojama laikytis gamintojo nurodymų dozavimo atžvilgiu ir laiku papildyti priemones, kad mikroorganizmai galėtų stabiliai veikti.
Taip pat svarbu užtikrinti, kad septikas būtų tinkamai prižiūrimas ir nevartotumėte cheminių medžiagų, kurios galėtų pakenkti bakterijų veiklai.
Jei ieškote kokybiškų biologinių bakterijų ar kitų priemonių, apsilankykite septikas.lt parduotuvėje.
Dažniausiai daromos klaidos prižiūrint septines sistemas
Priežiūros metu įvykusios klaidos gali smarkiai sumažinti septiko efektyvumą. Dažnai daroma klaida yra cheminių priemonių vartojimas kartu su biologinėmis, kas suardo natūralią mikroorganizmų pusiausvyrą.
Kita problema – netinkamas septiko valymas ir per mažas bakterijų papildymas, ypač sezoniškai arba kai sistemoje daug atliekų.
Nuolatinis sistemingas valymas, bakterijų palaikymas ir atsakingas naudojimas padės išvengti nemalonių kvapų, užsikišimų ir daug kitų problemų.
DUK
Kas yra biologinės bakterijos septikams?
Biologinės bakterijos yra naudingos mikroorganizmai, kurie greitai skaido organines atliekas ir padeda palaikyti septiko ekosistemą natūraliai ir efektyviai.
Kuo biologinės bakterijos skiriasi nuo cheminių priemonių?
Biologinės bakterijos veikia natūraliai, palaiko mikroorganizmų balansą, o cheminės priemonės dažnai agresyviai naikina ir naudinguosius mikrobus, ilgainiui gadindamos sistemą.
Kaip dažnai reikėtų naudoti biologines bakterijas septikams?
Rekomenduojama bakterijas naudoti pagal gamintojo nurodymus, dažniausiai kas 1-2 savaites reguliariai, kad užtikrinti optimalų veikimą ir prevenciją nuo kamščių.
Daugiau naudingos informacijos apie nuotekų valymą rasite šioje Wikipedia nuotekų valymo straipsnyje.
Jei norite sužinoti daugiau apie septikų priežiūrą, apsilankykite mūsų verta žinoti skyriuje.